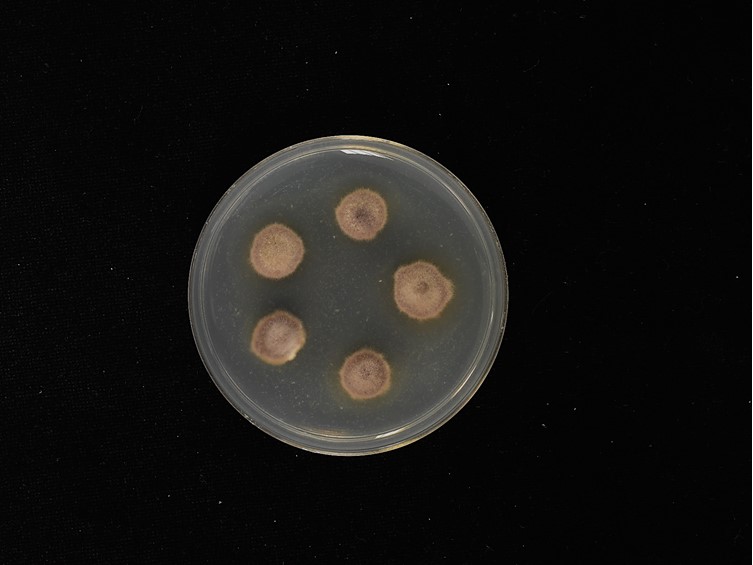

Holotype:
THAILAND, Samut Songkhram Province, Boonmee Orchard, 31 Jan. 2017, K. Tasanathai, P. Srikitikulchai, R. Promharn, S. Mongkolsamrit, holotype BBH 42350, ex-type living culture BCC 84256.
Habitat:
Underside of pomelo leaves (Citrus maxima).
Host:
Leafhopper.
Description:
 Mycelium covering loosely the leafhopper with compact pale yellow to orange hyphae and surrounded by a radiating mat over the leaf. Conidiogenous structures phialidic, borne directly and singly on hyphae.
Mycelium covering loosely the leafhopper with compact pale yellow to orange hyphae and surrounded by a radiating mat over the leaf. Conidiogenous structures phialidic, borne directly and singly on hyphae.  Phialides cylindrical or flask-shaped, basal portion, 7-20 × 2-4 μm, tapering into a long neck, 4-10 × 1 μm.
Phialides cylindrical or flask-shaped, basal portion, 7-20 × 2-4 μm, tapering into a long neck, 4-10 × 1 μm.  Conidia smooth-walled, one-celled, hyaline, fusiform to globose, apiculate on distal end, 2-5 × 2-3 μm.
Conidia smooth-walled, one-celled, hyaline, fusiform to globose, apiculate on distal end, 2-5 × 2-3 μm.
Culture characteristics:
Colonies on PDA attaining a diam of 8 mm in 14 d, cottony with high mycelial density, greyish purple. Mycelium smooth-walled, septate, hyaline. Conidiogenous structures phialidic, borne directly and singly on hyphae. Phialides 8–20 × 3–4 μm, with cylindrical basal portion, tapering predominantly into a long neck or occasionally producing two to three necks, 3–10 × 1 μm. Conidia smooth-walled, one-celled, hyaline, fusiform to globose, apiculate on distal end, 2–3 × 2–3 μm.
Colonies on PDA attaining a diam of 8 mm in 14 d, cottony with high mycelial density, greyish purple. Mycelium smooth-walled, septate, hyaline. Conidiogenous structures phialidic, borne directly and singly on hyphae. Phialides 8–20 × 3–4 μm, with cylindrical basal portion, tapering predominantly into a long neck or occasionally producing two to three necks, 3–10 × 1 μm. Conidia smooth-walled, one-celled, hyaline, fusiform to globose, apiculate on distal end, 2–3 × 2–3 μm.
Reference:
Mongkolsamrit S, Noisripoom W, Pumiputikul S, et al.( 2021). Ophiocordyceps flavida sp. nov. (Ophiocordycipitaceae), a new species from Thailand associated with Pseudogibellula formicarum (Cordycipitaceae), and their bioactive secondary metabolites. Mycological Progress 20: 477–492.
DOI: https://doi.org/10.1007/s11557-021-01683-ySpecies |
Strain |
Compound |
Pubchem CID |
Biological activity |
Reference |
|---|
|
Strain |
LSU | RPB1 | TEF1 |
|---|---|---|---|
| BCC 84255 | MT512654 | - | - |
| BCC 84256 | MT512655 | MT533476 | MT533482 |
| BCC 84263 | MT512656 | MT533477 | MT533483 |